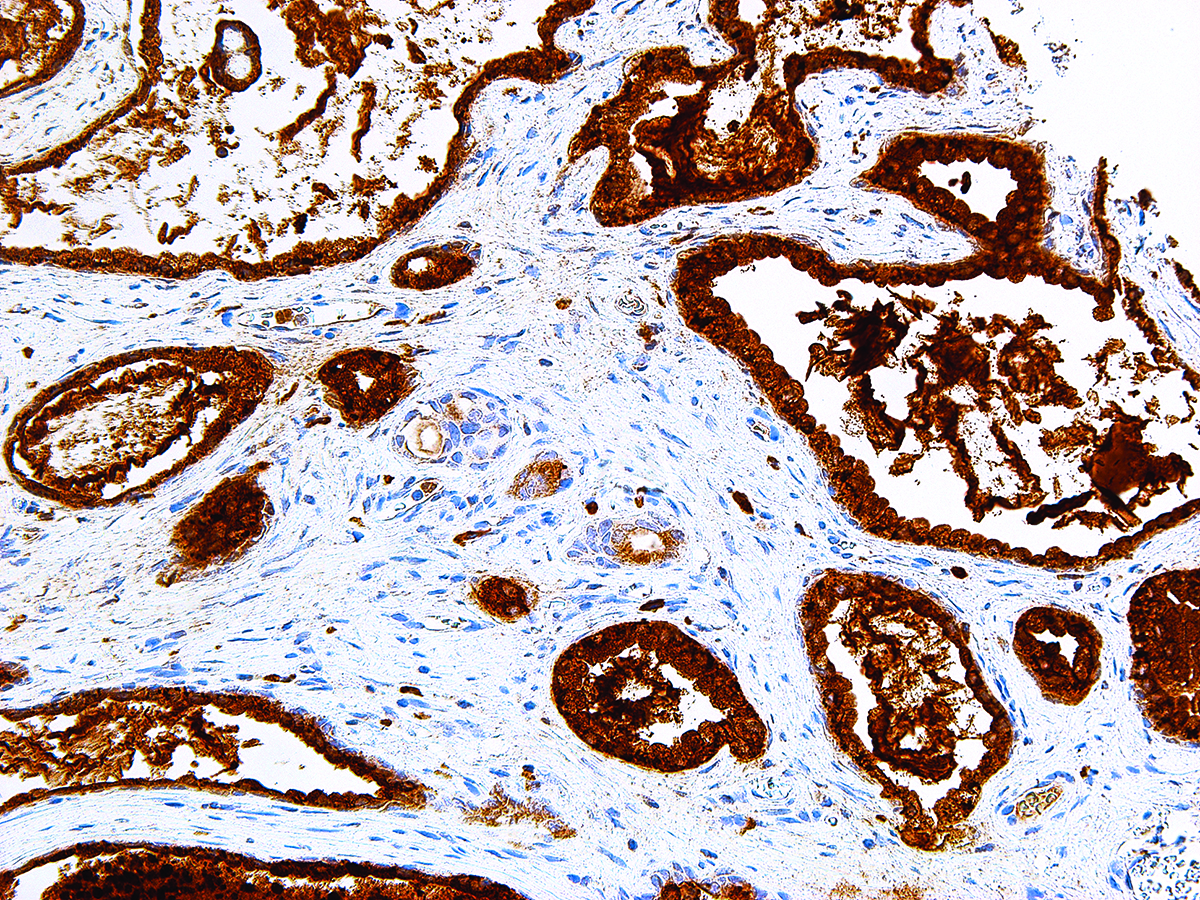

[Genomeme] PSAP
Cat. No.
IHC655-100
Specifications
| Clone | IHC655 |
| Source | Mouse Monoclonal |
| Positive Control | Prostate, Prostate Adenocarcinoma |
| Dilution Range | 1:50-1:200 |
Description
Prostatic Specific Acid Phosphatase (PSAP) is a prostatic enzyme found in the glandular epithelium of the prostate. PSAP levels are elevated in hyperplastic prostate and prostate carcinoma, with the highest levels being detected in metastasized prostate cancer. Moderate overexpression of PSAP is also characteristic of diseases of the bone (such as Paget’s disease or hyperparathyroidism), diseases of blood cells (such as sickle-cell disease), multiple myeloma, or lysosomal storage diseases (such as Gaucher’s disease). PSAP is considered more sensitive, yet less specific, than PSA, however Anti-PSAP can act as a useful complement to Anti-PSA under suitable clinical contexts.
'Genomeme' 카테고리의 다른 글
| [Genomeme] Annexin A1 (0) | 2020.09.14 |
|---|---|
| [Genomeme] CD5 (0) | 2020.08.21 |
| [Genomeme] Survivin (0) | 2020.05.29 |
| [Genomeme] Annexin A1 (0) | 2020.01.16 |
| [Genomeme] CDX-2 (0) | 2019.12.31 |